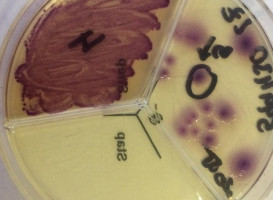

FarmVet spol. s r.o.
- IČ: 05351804
- DIČ: CZ05351804
|
Adresa provozovny
Sídlo společnosti |
Nádražní 399, 38301 Prachatice
Rojšín 5, 38203 Brloh |
|
Telefon
|
+420 725 956 264 |
|
Telefon
|
+420 725 956 264 |
|
E-mail
|
[email protected] |
|
Web
|
farmvet.cz |
Fotografie této firmy
Další pobočky
* Informace o této společnosti pochází z veřejně dostupných zdrojů a rejstříků a nemusí být zcela přesné.

B. Němcové 806, 39811 Protivín
B. Němcové 806, 39811 Protivín

